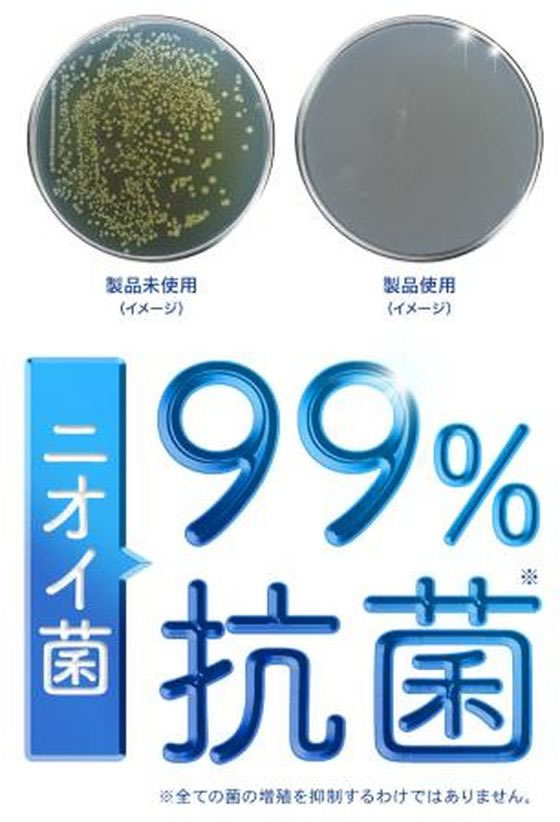
�ڥ�ӥ塼��Ƥ�100��OFF�����ݥ�ۥɥ����������硼�� �ý������ݷ����ץ졼 ̵���� 150mL ���� ���� ���塼�� ���ѻ���

靴
KNOWLEDGE
生活百科
HOME > 靴ケア用品・アクセサリー > 消臭・防臭用品
|
5294件|3ページ/100ページ|
<-- 前のページへ 次のページへ --> |
 靴 消臭スプレー 通販 消臭 スプレー 靴スプレー 逆さで使える消臭スプレー 450ml C070-0098 長靴 ブーツ イズフィット is-fit Ag 抗菌 モリト is−fit イズ・フィット シューズ関連小物 靴 消臭スプレー 通販 消臭 スプレー 靴スプレー 逆さで使える消臭スプレー 450ml C070-0098 長靴 ブーツ イズフィット is-fit Ag 抗菌 モリト is−fit イズ・フィット シューズ関連小物 シューケア用品 靴ケア用品
靴 消臭スプレー 通販 消臭 スプレー 靴スプレー 逆さで使える消臭スプレー 450ml C070-0098 長靴 ブーツ イズフィット is-fit Ag 抗菌 モリト is−fit イズ・フィット シューズ関連小物 靴 消臭スプレー 通販 消臭 スプレー 靴スプレー 逆さで使える消臭スプレー 450ml C070-0098 長靴 ブーツ イズフィット is-fit Ag 抗菌 モリト is−fit イズ・フィット シューズ関連小物 シューケア用品 靴ケア用品 [ショップ:BACKYARD FAMILY ママタウン] [ショップコード:backyard]
価格:1,552円 税込 送料別 クレジットカード利用可 海外配送不可 翌日配送不可 ギフト包装不可
〜ご利用シーン・イベント〜 下記ご利用シーンやイベントなどでご使用することが可能です。 ※一部イベント等はご使用頂けない場合がございます。 お正月 初売り 初詣 お年玉 成人の日 成人式 節分 バレンタインデー 桃の節句(ひなまつり) ホワイトデー 春物入荷 お花見 入学式 ゴールデンウィーク 母の日 衣替え 父の日 梅雨 夏物入荷 山開き 海開き 七夕 お中元 暑中お見舞い 夏休み 花火大会 盆踊り 夏祭り 秋物入荷 防災 敬老の日 ハロウィン 運動会 文化祭 学園祭 お歳暮 冬物入荷 クリスマス プレゼント 贈物 贈り物 ギフト お返し 引っ越し祝い 新生活 お祝い 内祝い 出産祝い 引っ越し祝い 引越し祝い 引越祝い 新築祝い 成人祝い 卒業祝い 就職祝い 合格祝い 入園祝い 入学祝い 進学祝い 結婚祝い 婚約祝い 退院祝い ボーナス祝い 七五三祝い 退職祝い 還暦祝い 長寿祝い 誕生日 お誕生日 大掃除ITEM DETAILSブランド名is-fit(イズフィット)商品名is-fit 逆さで使える消臭スプレー商品説明【長靴やブーツにシュッと噴射】・長さのあるシューズも、簡単に消臭&除菌◎「is-fit 逆さで使える消臭スプレー」。【つま先までしっかり噴射できて便利】・逆さで使用OK!奥までしっかりスプレーでき、パウダー配合で靴の中もサラサラ感が持続。【ニオイさよなら、いつも清潔】・抗菌効果のあるAgと、消臭効果のある針葉樹抽出成分。嫌なニオイに働きかけ菌の増殖も防ぐ◎(※)靴内のあらゆる菌を除菌するものではありません。【家庭に1つあると頼れる450ml】・片足3秒、両足6秒の噴射で約120日分の容量。デイリーに使えて、家族でシェアも!生産国日本サイズ※内容量は「容量欄」をご確認ください。重量約394g成分針葉樹抽出物、銀系抗菌剤(パウダー)、アルコール容量450ml注意点※お取り扱いの際は、商品やパッケージなどに記載されている品質表示、アテンションタグ、ご使用上の注意事項などを必ずご確認下さい。※本来の目的以外にはご使用にならないで下さい。※カメラやモニターの性質により、画像と実物の色の違いがある場合がございますのでご理解願います。
 靴用消臭剤 DRY NOW ドライナウ 通販 靴用 除湿剤 70g 6パック 3足分 靴専用 脱臭 乾燥 ニオイ対策 繰り返し 運動靴 ブーツ レディース メンズ キッズ 活性炭 シリカゲル 消臭 調湿 靴用消臭剤 DRY NOW ドライナウ 通販 靴用 除湿剤 70g 6パック 3足分 靴専用 脱臭 乾燥 ニオイ対策 繰り返し 運動靴 ブーツ レディース メンズ キッズ 活性炭 シリカゲル 消臭 調湿 シューケア
靴用消臭剤 DRY NOW ドライナウ 通販 靴用 除湿剤 70g 6パック 3足分 靴専用 脱臭 乾燥 ニオイ対策 繰り返し 運動靴 ブーツ レディース メンズ キッズ 活性炭 シリカゲル 消臭 調湿 靴用消臭剤 DRY NOW ドライナウ 通販 靴用 除湿剤 70g 6パック 3足分 靴専用 脱臭 乾燥 ニオイ対策 繰り返し 運動靴 ブーツ レディース メンズ キッズ 活性炭 シリカゲル 消臭 調湿 シューケア [ショップ:BACKYARD FAMILY ママタウン] [ショップコード:backyard]
価格:1,525円 税込 送料込 クレジットカード利用可 海外配送不可 翌日配送不可 ギフト包装不可
〜ご利用シーン・イベント〜 下記ご利用シーンやイベントなどでご使用することが可能です。 ※一部イベント等はご使用頂けない場合がございます。 お正月 初売り 初詣 お年玉 成人の日 成人式 節分 バレンタインデー 桃の節句(ひなまつり) ホワイトデー 春物入荷 お花見 入学式 ゴールデンウィーク 母の日 衣替え 父の日 梅雨 夏物入荷 山開き 海開き 七夕 お中元 暑中お見舞い 夏休み 花火大会 盆踊り 夏祭り 秋物入荷 防災 敬老の日 ハロウィン 運動会 文化祭 学園祭 お歳暮 冬物入荷 クリスマス プレゼント 贈物 贈り物 ギフト お返し 引っ越し祝い 新生活 お祝い 内祝い 出産祝い 引っ越し祝い 引越し祝い 引越祝い 新築祝い 成人祝い 卒業祝い 就職祝い 合格祝い 入園祝い 入学祝い 進学祝い 結婚祝い 婚約祝い 退院祝い ボーナス祝い 七五三祝い 退職祝い 還暦祝い 長寿祝い 誕生日 お誕生日 大掃除ITEM DETAILSブランド名DRY NOW ドライナウ商品名ドライナウ 靴用 3足分(70g×6パック入り) 商品説明調湿効果に優れた特殊なシリカゲルに活性炭を配合した靴専用の乾燥・脱臭剤です。効果が弱くなった時は、天日に半日以上あてて干すことで繰り返しご使用できます。お取替えは開封後、約6ヶ月が目安です。生産国日本サイズ[縦]約15cm×[横]約8cm(個装サイズ)重量70g×6パック成分シリカゲル、活性炭注意点※カメラやモニターの性質により、画像と実物の色の違いがある場合がございますのでご理解願います。
 消臭スプレー 靴 2本セット 通販 オドクリーンスリム 180ml 消臭 スプレー 消臭剤 靴用 植物系消臭成分 Ag系抗菌剤 パウダースプレー さらさら におい消し ニオイ 中和 防臭スプレー 消臭スプレー 靴 2本セット 通販 オドクリーンスリム 180ml 消臭 スプレー 消臭剤 靴用 植物系消臭成分 Ag系抗菌剤 パウダースプレー さらさら におい消し ニオイ 中和 防臭スプレー せっけん 石鹸 無香料 クール COOL シトラスグリーン 柑橘系 グレープフルーツ ODOR CLEAN
消臭スプレー 靴 2本セット 通販 オドクリーンスリム 180ml 消臭 スプレー 消臭剤 靴用 植物系消臭成分 Ag系抗菌剤 パウダースプレー さらさら におい消し ニオイ 中和 防臭スプレー 消臭スプレー 靴 2本セット 通販 オドクリーンスリム 180ml 消臭 スプレー 消臭剤 靴用 植物系消臭成分 Ag系抗菌剤 パウダースプレー さらさら におい消し ニオイ 中和 防臭スプレー せっけん 石鹸 無香料 クール COOL シトラスグリーン 柑橘系 グレープフルーツ ODOR CLEAN [ショップ:BACKYARD FAMILY ママタウン] [ショップコード:backyard]
価格:2,568円 税込 送料込 クレジットカード利用可 海外配送不可 翌日配送不可 ギフト包装不可
〜ご利用シーン・イベント〜 下記ご利用シーンやイベントなどでご使用することが可能です。 ※一部イベント等はご使用頂けない場合がございます。 お正月 初売り 初詣 お年玉 成人の日 成人式 節分 バレンタインデー 桃の節句(ひなまつり) ホワイトデー 春物入荷 お花見 入学式 ゴールデンウィーク 母の日 衣替え 父の日 梅雨 夏物入荷 山開き 海開き 七夕 お中元 暑中お見舞い 夏休み 花火大会 盆踊り 夏祭り 秋物入荷 防災 敬老の日 ハロウィン 運動会 文化祭 学園祭 お歳暮 冬物入荷 クリスマス プレゼント 贈物 贈り物 ギフト お返し 引っ越し祝い 新生活 お祝い 内祝い 出産祝い 引っ越し祝い 引越し祝い 引越祝い 新築祝い 成人祝い 卒業祝い 就職祝い 合格祝い 入園祝い 入学祝い 進学祝い 結婚祝い 婚約祝い 退院祝い ボーナス祝い 七五三祝い 退職祝い 還暦祝い 長寿祝い 誕生日 お誕生日 大掃除ITEM DETAILSブランド名COLUMBUS(コロンブス)商品名COLUMBUS オドクリーンスリム 靴用消臭スプレー 2本セット商品説明・3ステップ消臭+パウダー機能で、靴のニオイを効果的に消臭・除菌!靴用消臭スプレー・オドクリーン2本セット。・植物系消臭成分が靴の中のイヤなニオイを中和。・Ag(銀)系抗菌剤が靴の中のニオイの元となるバクテリアの発生や繁殖を防ぐ!・シトラスグリーン、石けんの香り、グレープフルーツ、クールなメントールなど、さわやかな香りでニオイを包みこむ!香りに敏感な方には無香料がオススメ。・パウダースプレータイプでさらさら感が持続して、靴の中の快適さを効果的に保つ!・1足当たり約4秒のスプレーで、約40回使用できるので、お財布にやさしいコストパフォーマンス。・5種類の香りの中から、お好きな組み合わせの2本をチョイスできる♪生産国日本サイズ[高さ]約19cm [直径]約4cm※商品一本当たりのパッケージサイズを記載しています。※サイズは当店平置き実寸サイズです。実際の商品とは多少の誤差が生じる場合がございます。あらかじめご了承ください。重量約182g (※商品1本当たりの重量を記載しています。)成分銀系抗菌剤・植物抽出物・香料・エタノール容量1本:180ml使用方法※容器をよく振ってからご使用ください。※靴の内側に15cm20cm離してスプレーしてください。※靴の表側にスプレーしないでください。※多量にスプレーすると、白く残ることがありますのでご注意ください。※標準使用足数は約40足です(1足当たり約4秒)注意点※換気のよい所でご使用ください。※溶剤は引火性ですので、火気には十分注意してください。※人体には直接使用しないでください。※誤って目に入った場合は多量の水で洗ってください。※幼児や小鳥等のペットのいる所では使用しないでください。※暖房器具(ファンヒーター等)の周囲は、温度が上がり破裂する危険があるので置かないでください。※お子さまの手の届かないところで保管してください。※缶のサビを防ぐために、水回りや湿気の多い場所に置かないでください。※捨てる際には、火気のない屋外で噴射音が消えるまでガスを抜いてください。※カメラやモニターの性質により、画像と実物の色の違いがある場合がございますのでご理解願います。ご利用シーンプレゼント 贈り物 ギフト お返し 引っ越し祝い 新生活 お祝い 内祝い
 消臭スプレー 靴 180ml COLUMBUS コロンブス 通販 オドクリーンスリム 消臭 スプレー くつ 靴用 植物系消臭成分 Ag系抗菌剤 パウダースプレー さらさら におい消し ニオイ 中和 消臭スプレー 靴 180ml COLUMBUS コロンブス 通販 オドクリーンスリム 消臭 スプレー くつ 靴用 植物系消臭成分 Ag系抗菌剤 パウダースプレー さらさら におい消し ニオイ 中和 防臭スプレー せっけん 石鹸 無香料 ク
消臭スプレー 靴 180ml COLUMBUS コロンブス 通販 オドクリーンスリム 消臭 スプレー くつ 靴用 植物系消臭成分 Ag系抗菌剤 パウダースプレー さらさら におい消し ニオイ 中和 消臭スプレー 靴 180ml COLUMBUS コロンブス 通販 オドクリーンスリム 消臭 スプレー くつ 靴用 植物系消臭成分 Ag系抗菌剤 パウダースプレー さらさら におい消し ニオイ 中和 防臭スプレー せっけん 石鹸 無香料 ク [ショップ:BACKYARD FAMILY ママタウン] [ショップコード:backyard]
価格:1,697円 税込 送料込 クレジットカード利用可 海外配送不可 翌日配送不可 ギフト包装不可
〜ご利用シーン・イベント〜 下記ご利用シーンやイベントなどでご使用することが可能です。 ※一部イベント等はご使用頂けない場合がございます。 お正月 初売り 初詣 お年玉 成人の日 成人式 節分 バレンタインデー 桃の節句(ひなまつり) ホワイトデー 春物入荷 お花見 入学式 ゴールデンウィーク 母の日 衣替え 父の日 梅雨 夏物入荷 山開き 海開き 七夕 お中元 暑中お見舞い 夏休み 花火大会 盆踊り 夏祭り 秋物入荷 防災 敬老の日 ハロウィン 運動会 文化祭 学園祭 お歳暮 冬物入荷 クリスマス プレゼント 贈物 贈り物 ギフト お返し 引っ越し祝い 新生活 お祝い 内祝い 出産祝い 引っ越し祝い 引越し祝い 引越祝い 新築祝い 成人祝い 卒業祝い 就職祝い 合格祝い 入園祝い 入学祝い 進学祝い 結婚祝い 婚約祝い 退院祝い ボーナス祝い 七五三祝い 退職祝い 還暦祝い 長寿祝い 誕生日 お誕生日 大掃除ITEM DETAILSブランド名COLUMBUS コロンブス商品名コロンブス COLUMBUS オドクリーンスリム 靴用消臭スプレー商品説明コロンブスの消臭・除菌スプレー オドクリーンは、植物系の消臭成分が靴の中の嫌な臭いを中和、Ag(銀)系抗菌剤が靴の雑菌の繁殖を防ぎ、香りはさわやかなシトラスグリーン。パウダースプレーがさらさら感を持続させ靴の中を快適に保ちます。素材キャップ:PP フィルム:PP ボタン:PP生産国日本サイズ約9.5cm x 約4.5cm重量約182g成分銀系抗菌剤、植物抽出物、香料、エタノール容量180ml注意点※カメラやモニターの性質により、画像と実物の色の違いがある場合がございますのでご理解願います。〜ご利用シーン〜プレゼント 贈り物 ギフト お返し 引っ越し祝い 新生活 お祝い 内祝い
 DECO MAISON(デコメゾン)は「楽天SHOP OF THE MONTH 2019年12月」月間MVP受賞! Dr.Scholl ドクターショール 強力消臭・抗菌インソール (21.5〜28.0cm) 1足分(2枚入) 服飾雑貨 靴
DECO MAISON(デコメゾン)は「楽天SHOP OF THE MONTH 2019年12月」月間MVP受賞! Dr.Scholl ドクターショール 強力消臭・抗菌インソール (21.5〜28.0cm) 1足分(2枚入) 服飾雑貨 靴 [ショップ:DECO MAISON] [ショップコード:deco-maison]
価格:1,660円 税込 送料込 クレジットカード利用可 海外配送不可 翌日配送不可 ギフト包装不可
天然由来の消臭成分「クリーンガード(R)」が悪臭を強力に吸着・中和。さらに抗菌・防カビ成分「コーキンマスター(R)」が、372種類ものニオイの原因菌に効果を発揮し、再繁殖を阻止します。消臭+ニオイ菌の繁殖阻止によって消臭効果が長持ち☆【使用方法】(1)台紙の内側に靴のサイズ別に切り取り線を印刷した図があります。(2)靴のサイズに合わせて、ハサミで簡単にカットしてご使用いただけます。※靴のサイズはメーカーや靴のデザインにより多少異なりますので、最初は少し大きめにカットし、一度靴に合わせてからご使用ください。(3)布地面を上にしてご使用ください。(4)2足ご用意の上交互にご使用いただくと、より効果が長持ちします。サイズ個装サイズ:1×11×35.5cm重量個装重量:50g仕様対応サイズ:21.5〜28.0cm生産国中国強力消臭+ニオイ菌繁殖阻止!!消臭効果が長持ち♪
 DECO MAISON(デコメゾン)は「楽天SHOP OF THE MONTH 2019年12月」月間MVP受賞! Dr.Scholl ドクターショール ドクター・ショール消臭・抗菌靴スプレー (無香性タイプ) 150ml 服飾雑貨 靴
DECO MAISON(デコメゾン)は「楽天SHOP OF THE MONTH 2019年12月」月間MVP受賞! Dr.Scholl ドクターショール ドクター・ショール消臭・抗菌靴スプレー (無香性タイプ) 150ml 服飾雑貨 靴 [ショップ:DECO MAISON] [ショップコード:deco-maison]
価格:1,620円 税込 送料込 クレジットカード利用可 海外配送不可 翌日配送不可 ギフト包装不可
発生しているニオイを瞬時に除去する天然成分「オドミット」と、ニオイの元となる細菌、カビの発生を抑える新抗菌、防カビ成分「コーキンマスター」を配合。強力な消臭力とニオイ菌の繁殖を防ぐことで、靴の中をいつも新鮮でさわやかな状態に保ちます。あらゆるタイプの靴にご使用頂けます。内容量150mlサイズ個装サイズ:5×5×18cm重量個装重量:160g成分コーキンマスター(有機・無機複合系抗菌、防カビ・防藻材)、消臭剤、香料、イソプロピルメチルフェノール、エタノール仕様無香性製造国日本瞬間消臭+ニオイ菌の元を断つ進化型靴スプレー!!
 DECO MAISON(デコメゾン)は「楽天SHOP OF THE MONTH 2019年12月」月間MVP受賞! Dr.Scholl ドクターショール ドクター・ショール消臭・抗菌靴スプレー (ベビーパウダーの香り) 150ml 服飾雑貨 靴
DECO MAISON(デコメゾン)は「楽天SHOP OF THE MONTH 2019年12月」月間MVP受賞! Dr.Scholl ドクターショール ドクター・ショール消臭・抗菌靴スプレー (ベビーパウダーの香り) 150ml 服飾雑貨 靴 [ショップ:DECO MAISON] [ショップコード:deco-maison]
価格:1,620円 税込 送料込 クレジットカード利用可 海外配送不可 翌日配送不可 ギフト包装不可
発生しているニオイを瞬時に除去する天然成分「オドミット」と、ニオイの元となる細菌、カビの発生を抑える新抗菌、防カビ成分「コーキンマスター」を配合。強力な消臭力とニオイ菌の繁殖を防ぐことで、靴の中をいつも新鮮でさわやかな状態に保ちます。あらゆるタイプの靴にご使用頂けます。【使用方法】・よく振って、靴から10cm以上離してお使いください。・スプレー後、1〜2分してから靴を履いてください。・足や皮膚には直接使用しないで下さい。(エアゾール缶/LPガス使用)【使用上の注意】●幼児の手の届かないところに保管してください。●靴用ですので、足やその他の皮膚には直接使用しないでください。●アルコールの成分により靴の中の塗装及びコーティングがはがれる場合があります。●水まわりや湿気の多い場所に置くと、缶が錆びて破裂する危険があります。●捨てる時は、火気のない屋外で噴射音が消えるまでボタンを押してガスを抜いてください。内容量150mlサイズ個装サイズ:4.5×4.5×17.5cm重量個装重量:160g成分コーキンマスター(有機・無機複合系抗菌、防カビ・防藻材)、消臭剤、香料、イソプロピルメチルフェノール、エタノール仕様ベビーパウダーの香り生産国日本瞬間消臭+ニオイ菌の元を断つ進化型靴スプレー!!
 DECO MAISON(デコメゾン)は「楽天SHOP OF THE MONTH 2019年12月」月間MVP受賞! Collonil(コロニル) カーボンオドクリーナー 125ml 服飾雑貨 靴
DECO MAISON(デコメゾン)は「楽天SHOP OF THE MONTH 2019年12月」月間MVP受賞! Collonil(コロニル) カーボンオドクリーナー 125ml 服飾雑貨 靴 [ショップ:DECO MAISON] [ショップコード:deco-maison]
価格:2,130円 税込 送料込 クレジットカード利用可 海外配送不可 翌日配送不可 ギフト包装不可
シューズだけでなく、バッグ内の嫌なにおい、キャップやジャケットなどのウェアに付着した皮脂や汗、タバコのにおいも素早く解消し、フレッシュな状態を保ちます。においの元とにおいそのものにWで効く!(1)アルコールがにおいの元となる雑菌を除菌します。(2)リシノール酸亜鉛がにおいを吸着、解消します。洗濯物の生乾き臭にも効果的です。シトラスマリンの爽やかな香り。サイズ個装サイズ:5×15.5×5cm重量個装重量:300g仕様危険等級II 第4類アルコール類 48ml火気厳禁生産国ドイツバッグ・ウェア・キャップにも使える除菌・消臭スプレー。
 【お取り寄せ】【税込1万円以上で送料無料】 【お取り寄せ】小林製薬 オドイーター 足臭対策 革風仕立て フットケア バス ボディケア スキンケア
【お取り寄せ】【税込1万円以上で送料無料】 【お取り寄せ】小林製薬 オドイーター 足臭対策 革風仕立て フットケア バス ボディケア スキンケア [ショップ:JET PRICE] [ショップコード:jetprice]
価格:598円 税込 送料別 クレジットカード利用可 海外配送不可 翌日配送不可 ギフト包装不可
【商品説明】<製品特徴>本革感覚で高級ビジネスシューズにピッタリ!オドイーター足臭対策の表面基布は、革に近い風合いに仕上げました。高級ビジネスシューズに敷いても違和感無くぴったりマッチし、履き心地も抜群な「足のニオイ」対策のことを考えて作られた消臭中敷です。【仕様】●サイズ:フリーサイズ20.0〜28.0cm●容量:1枚●生産国:日本【検索用キーワード】小林製薬 オドイーター 足臭対策 革風仕立て コバヤシセイヤク こばやしせいやく 効果 評判 口コミ 使用感 臭い対策 足の臭い対策 S14522本革感覚で高級ビジネスシューズにピッタリ
 【お取り寄せ】【税込3980円以上で送料無料】 【レビュー投稿で100円OFFクーポン】【お取り寄せ】小久保工業所 竹炭 シューズ用 50g×2個 KM-470 日用雑貨
【お取り寄せ】【税込3980円以上で送料無料】 【レビュー投稿で100円OFFクーポン】【お取り寄せ】小久保工業所 竹炭 シューズ用 50g×2個 KM-470 日用雑貨 [ショップ:ココデカウ] [ショップコード:cocodecow]
価格:188円 税込 送料別 クレジットカード利用可 海外配送不可 翌日配送不可 ギフト包装不可
【商品説明】厳選した孟宗竹(モウソウチク)を独自の製法で生成した炭を不織布でカバーし、手軽に使える天然素材の除湿・消臭剤にしました。靴を脱いだ後、1足に1個ずつ入れて使用します。靴のイヤ〜な臭い対策に。靴のジメジメした湿気対策に。1週間に1回程度の天日干しで効果が回復します。【仕様】●サイズ:縦220×横145×奥行25mm●材質:孟宗竹●注文単位:1袋(50g×2個)●生産国:中国【使用方法】・パッケージを開け、内袋から本品をとり出し、白い不織布袋のままご使用ください。・靴の形が崩れない程度に、竹炭をできるだけ靴の奥まで入れてご使用ください。・内袋に結露した水滴がついている場合があります。その場合は、天日干しをしてからご使用ください。品質には問題ございません。【注意事項】・本来の用途以外に使用しないでください。・1週間に1回を目安に天日干ししてください。天日干しすると効果が回復し、くり返し使用できます。・使用の目安として、3カ月程度で新しい商品とお取り替えください。・使用済みの竹炭は、捨てずに、中身を取り出し、植木鉢、花壇などの土に混ぜて、土壌改良剤として使用できます。・使用済みの竹炭を、燃料用として使用しないでください。・食品用として使用しないでください。・火気の近く、高温になる場所に置かないでください。・小さなお子さまの手の届かないところに保管してください。【備考】※メーカーの都合により、パッケージ・仕様等は予告なく変更になる場合がございます。【検索用キーワード】小久保工業所 コクボコウギョウショ こくぼこうぎょうしょ KOKUBO 竹炭シューズ用50g×2個 竹炭 シューズ用 50g×2個 ちくたんしゅーずよう チクタンシューズヨウ シューズ用消臭剤 靴用消臭剤 1袋 2個 革靴 スニーカー ショートブーツ 雨靴 スリッパ 竹炭効果 ちくたんこうか KM−470 孟宗竹 もうそうちく モウソウチク 不織布 ふしょくふ 天然素材 SDGs エスディージーズ 除湿 じょしつ 消臭 しょうしゅう その他日用品 その他日用品 R293JE天然素材「竹炭」で湿度を調節、臭いもスッキリ!
 【3980円以上 送料無料】 マーキープレイヤー MARQUEE PLAYER 除菌消臭スプレー MARQUEE PLAYER SNEAKER REVIVER ANCHOR No.06 マーキープレイヤー 消臭スプレー 靴 除菌 シューケア シューズケア 靴ケア用品 ケア MP004 【海外発送不可】
【3980円以上 送料無料】 マーキープレイヤー MARQUEE PLAYER 除菌消臭スプレー MARQUEE PLAYER SNEAKER REVIVER ANCHOR No.06 マーキープレイヤー 消臭スプレー 靴 除菌 シューケア シューズケア 靴ケア用品 ケア MP004 【海外発送不可】 [ショップ:Findoriy] [ショップコード:biget]
価格:1,980円 税込 送料別 クレジットカード利用可 海外配送可能 ワールドワイド 翌日配送不可 ギフト包装不可 ポイント倍付:10倍:2025-12-12 07:00〜9999-12-31 23:59
商品説明 【シューズケアに特化したプロダクトを開発する新鋭ブランドMARQUEE PLAYER】 ・シューズ用の除菌消臭スプレー。 ・雨の日などの湿気が多い日や定期的なメンテナンスの時にピッタリなアイテム。 ・ユーカリエキスを配合し清涼感ある香りになっています。 ・サイズが小さいので持ち運びもでき、出先でも使うことができます。 ブランド名 / 商品名 MARQUEE PLAYER マーキープレイヤー / SNEAKER REVIVER ANCHOR No.06 MP004 生産国 JAPAN 内容量 120ml 使用方法 1.スニーカーの塗布面の汚れを取ってから、15-20cm位離してムラなく表面が湿る程度にスプレーしてください。 2.スプレー後は、よく乾かしてください。※汚れがあると、汚れが原因の輪ジミを起こす場合があります。 類似商品はこちらMARQUEE PLAYER SNEAKER 1,980円MARQUEE PLAYER SNEAKER 1,980円MARQUEE PLAYER SNEAKER 1,980円MARQUEE PLAYER SNEAKER 1,980円MARQUEE PLAYER RUBBER S1,100円マーキープレイヤー For SNEAKER P1,870円マーキープレイヤー For SNEAKER C1,800円マーキープレイヤー RUBBER+SOLE E1,000円MARQUEE PLAYER WATER ST2,420円新着商品はこちら2026/2/26anello LYRA CROSS BODY 6,050円2026/2/26anello NIMBUS CROSSBODY6,050円2026/2/26anello NIMBUS TOTE BACK6,490円再販商品はこちら2026/2/26Goods Lab グッズラボ 掛け布団 掛布7,100円2026/2/26毛布 ブランケット もこもこ エアロゲルヒート5,500円2026/2/26ソファパッド ソファーカバー 毛布 ブランケッ3,500円〜2026/02/26 更新類似商品はこちらMARQUEE PLAYER SNEAKER 1,980円MARQUEE PLAYER SNEAKER 1,980円MARQUEE PLAYER SNEAKER 1,980円新着商品はこちら2026/2/26anello LYRA CROSS BODY 6,050円2026/2/26anello NIMBUS CROSSBODY6,050円2026/2/26anello NIMBUS TOTE BACK6,490円再販商品はこちら2026/2/26Goods Lab グッズラボ 掛け布団 掛布7,100円2026/2/26毛布 ブランケット もこもこ エアロゲルヒート5,500円2026/2/26ソファパッド ソファーカバー 毛布 ブランケッ3,500円〜
 【税込3980円以上で送料無料】 【レビュー投稿で100円OFFクーポン】エステー 脱臭炭 こわけ 下駄箱用 3個入 脱臭剤 除湿 脱臭剤 殺虫 防虫剤
【税込3980円以上で送料無料】 【レビュー投稿で100円OFFクーポン】エステー 脱臭炭 こわけ 下駄箱用 3個入 脱臭剤 除湿 脱臭剤 殺虫 防虫剤 [ショップ:ココデカウ] [ショップコード:cocodecow]
価格:474円 税込 送料別 クレジットカード利用可 海外配送不可 翌日配送不可 ギフト包装不可
【仕様】ゼリー状炭(備長炭、活性炭)がしっかり脱臭!ミネラル系抗菌剤配合。小さくなるゼリー状の炭で交換時期が分かる!●下駄箱用●成分:活性炭、備長炭、ミネラル系抗菌●内容量:標準55g×3個(165g)●使用期間:通常約1〜2ヶ月(環境により異なります)【備考】※メーカーの都合により、パッケージ・仕様等は予告なく変更になる場合がございます。【検索用キーワード】脱臭剤 消臭剤 芳香剤 除菌剤 下駄箱用 エステー 炭 備長炭 小分け 脱臭ゼリー 消臭ゼリー ニオイ消し 脱臭剤 匂い におい 1箱 3個 60日 押入 くつ箱 くつばこ 靴収納 水捨て 収納庫 梅雨 活性炭 ミネラル 抗菌剤 吸湿 RPUP_02 R28644備長炭パワー!3個で下駄箱すみずみ脱臭!
 【3980円以上で注文可能】ノンスメル くつ用スプレー せっけんの香り 145mL
【3980円以上で注文可能】ノンスメル くつ用スプレー せっけんの香り 145mL [ショップ:カマクラストアー おまとめ館] [ショップコード:sinca-ism-2]
価格:740円 税込 送料別 クレジットカード利用可 海外配送不可 翌日配送不可 ギフト包装不可
【商品名】 ノンスメル くつ用スプレー せっけんの香り 【このような場合に】 一日はいた靴の中の気になるニオイに。 【保管上の注意】 高温にすると破裂の危険があるため、 直射日光の当たる所や火気等の近くなど温度が40度以上となる所に置かないでください。 【消費者相談窓口】 白元アース株式会社お客様相談室 電話:03-5681-7691 受付時間:月曜〜金曜 午前9:00〜午後5:00(祝祭日を除く) ※別途休業期間、年末年始休業期間あり 【製造販売会社】 白元アース 【ご使用について】 【商品の使い方】 (1)中央の白いつまみをOPENのところまで回してお使いください。 (2)容器をよく振ってからご使用ください。 (3)靴から10cm位離してお使いください。 ※スプレー後に靴をはく時は、乾いていることを確認してからはいてください。 ※1秒の噴射で約150回使用できます。 【使用上の注意】 (1)暖房器具の周辺等火気の近くでは使用しない。 (2)換気のよい場所で使用する。 (3)靴の外側にスプレーしない。 (4)アルコールの成分により靴の中の塗装及びコーティングがはがれる場合がある。 (5)人体には使用しない。 (6)幼児のいる所では使用しない。 (7)パウダー成分が白く残る場合があるので、一カ所に集中してスプレーしない。 (8)用途以外に使用しない。 【応急処置】 (1)目に入った場合は、すぐ流水で充分洗い流す。 (2)口に入った場合は、水で口の中をよくすすぐ。 (3)皮フについた場合は、水で洗い流す。 【火気と高温に注意】 ※高圧ガスを使用した可燃性の製品であり、危険なため、下記の注意を守ること。 (1)炎や火気の近くで使用しないこと。 (2)火気を使用している室内で大量に使用しないこと。 (3)火の中に入れないこと。 (4)使い切って捨てること。 (高圧ガス/DME) 【素材】 エタノール、IPMP(除菌剤)、両性界面活性剤系消臭剤、香料 製品の特徴 ●白元アース NONSMEL ノンスメル くつ用スプレー ●一日はいた靴の中の気になるニオイを消臭し、除菌(*)します。ニオイを次の日まで持ち越しません。 [*すべての菌を除菌するわけではありません。] ●速乾処方なので、出かける前のニオイケアにも。 ●パウダーインでサラサラ。 ●爽やかなせっけんの香り。 ●逆さにしてもスプレーできます。 ●品名:消臭芳香剤 ●用途:くつ用
 【3980円以上で注文可能】ノンスメルドライ 下駄箱用 せっけんの香り 1個入
【3980円以上で注文可能】ノンスメルドライ 下駄箱用 せっけんの香り 1個入 [ショップ:カマクラストアー おまとめ館] [ショップコード:sinca-ism-2]
価格:690円 税込 送料別 クレジットカード利用可 海外配送不可 翌日配送不可 ギフト包装不可
【商品名】 ノンスメルドライ 下駄箱用 せっけんの香り 【このような場合に】 【用途】 下駄箱内の湿気とり・ニオイとり 【保管上の注意】 本品をすぐに使用しない時は、直射日光を避けて、外袋を開けずに保存してください。 【製造販売会社】 白元アース 【ご使用について】 【使用方法】 ・外袋から本品を取り出し、そのまま下駄箱の端に置いてください。 ・背面の窓から見える薬剤がゼリー状になったら新しい『ノンスメルドライ下駄箱用』とお取り替えください。 ・密閉性の高い環境でご使用いただくと、より効果的です。 【使用基準】 下駄箱250Lに1個を目安にお使いください。 〈容量目安サイズ…幅75×高さ95×奥行35cm〉 【使用上の注意】 ・中の薬剤を取り出さないでください。 ・お子様がいたずらしないようご注意ください。 ・薬剤を口にした場合は、水で口の中を洗浄し、コップ1〜2杯の水を飲ませてください。また、皮フに付いたり、目に入った場合は、すぐに多量の水で洗い流してください。どちらの場合も、異常があれば医師にご相談ください。 ・薬剤を衣類や金属などについたままにしておくと、変色・変質・サビの原因となりますので、水でよく洗い流してください。洗えない場合は、ベトつきがなくなるまで水拭きとカラ拭きを繰り返してください。 ・特に湿気の多い場合、一時的に薬剤がゼリー状にならず液体がたまることがあります。また、温度や湿度が低い時には、使用中に薬剤が固まることがあります。どちらの場合も効果や品質には問題ございませんので、そのままご使用ください。 ・用途以外に使用しないでください。 【素材】 塩化カルシウム、保水剤(天然由来成分)、香料、活性炭 製品の特徴 ●白元アース ノンスメルドライ 下駄箱用 せっけんの香り ●除湿&脱臭 ●下駄箱内に置くだけで、じめじめとイヤなニオイがスッキリします。 ●場所をとらないコンパクトでおしゃれなケース。そのまま下駄箱に置けます。 ●爽やかなせっけんの香りが広がります。 ●ゼリー状に固まるタイプ。 ●天然由来成分の保水剤使用。 ●用途:下駄箱内の湿気とり・ニオイとり ●使用期間:1〜5か月(同じ使用場所でも季節や湿気の状態で異なります。) ※使用開始後1年以内に必ず新しい商品とお取り替えください。 ●標準除湿量(水換算):約120g(温度25℃、湿度80%の場合)
 【税込3980円以上で送料無料】 【レビュー投稿で100円OFFクーポン】ドクター・ショール 消臭・抗菌靴スプレー BP 150mL ケア くつ シューズ 日用雑貨
【税込3980円以上で送料無料】 【レビュー投稿で100円OFFクーポン】ドクター・ショール 消臭・抗菌靴スプレー BP 150mL ケア くつ シューズ 日用雑貨 [ショップ:ココデカウ] [ショップコード:cocodecow]
価格:1,085円 税込 送料別 クレジットカード利用可 海外配送不可 翌日配送不可 ギフト包装不可
【商品説明】あらゆるタイプの履物に使える、消臭、抗菌の靴スプレー。消臭、抗菌、防カビ成分「コーキンマスター」が靴の中のニオイの元となる細菌、カビの繁殖を徹底的に抑えます。すでに発生しているニオイも98%を瞬時に除去。天然消臭成分を配合した、ベビーパウダーの香りです。【仕様】●ベビーパウダーの香り●注文単位:1本【備考】※メーカーの都合により、パッケージ・仕様等は予告なく変更になる場合がございます。【検索用キーワード】しょーるずうぇるねすかんぱにー ショールズウェルネスカンパニー SHOLL’S WELLNESS COMPANY SHOLLSWELLNESSCOMPANY 消臭スプレーBP しょうしゅうすぷれーBP ショウシュウスプレーBP 消臭スプレー 靴スプレー 1 個 靴用消臭スプレー 228619 スプレー ドクターショール Dr.ショール Dr.scholl drscholl どくたーしょーる Dr.ショール消臭抗菌靴スプレーBP150mL Dr.ショール 消臭抗菌靴スプレー BP 靴スプレー 消臭スプレー 抗菌スプレー 靴用 ベビーパウダーの香り コンパクトサイズ 消臭 抗菌 防カビ コーキンマスター 日用雑貨 くつシューズ用品 R1900C成分コーキンマスターにより、ニオイを瞬間消臭し、細菌・カビの再繁殖を阻止。
【税込3980円以上で送料無料】 【レビュー投稿で100円OFFクーポン】ドクター・ショール 消臭・抗菌靴スプレー 無香性 150mL ケア くつ シューズ 日用雑貨
【税込3980円以上で送料無料】 【レビュー投稿で100円OFFクーポン】ドクター・ショール 消臭・抗菌靴スプレー 無香性 150mL ケア くつ シューズ 日用雑貨 [ショップ:ココデカウ] [ショップコード:cocodecow]
価格:1,085円 税込 送料別 クレジットカード利用可 海外配送不可 翌日配送不可 ギフト包装不可
【商品説明】瞬間消臭+ニオイ菌繁殖阻止。消臭、抗菌、防カビ成分「コーキンマスター」が靴のニオイの元となる細菌、カビの繁殖を徹底的に抑えます。発生しているニオイも98%瞬時に除去。天然消臭成分配合。無香性タイプ。あらゆるタイプの履物にご使用いただけます。【仕様】●無香性●注文単位:1本【備考】※メーカーの都合により、パッケージ・仕様等は予告なく変更になる場合がございます。【検索用キーワード】しょーるずうぇるねすかんぱにー ショールズウェルネスカンパニー SHOLL’S WELLNESS COMPANY SHOLLSWELLNESSCOMPANY 消臭スプレー しょうしゅうすぷれー ショウシュウスプレー 消臭スプレー 靴スプレー 1 個 靴用消臭スプレー 222525 スプレー ドクターショール Dr.ショール Dr.scholl drscholl どくたーしょーる Dr.ショール消臭抗菌靴スプレー無香性150mL Dr.ショール 消臭抗菌靴スプレー 無香性 靴スプレー 消臭スプレー 抗菌スプレー 靴用 天然消臭成分 ニオイ消臭 コンパクトサイズ 消臭 抗菌 防カビ コーキンマスター 日用雑貨 くつシューズ用品 R1898Cニオイを瞬間消臭し、細菌・カビの再繁殖を阻止。
 【お取り寄せ】【税込3980円以上で送料無料】 【レビュー投稿で100円OFFクーポン】【お取り寄せ】ドクター・ショール 消臭・抗菌靴スプレー 無香性 300mL ケア くつ シューズ 日用雑貨
【お取り寄せ】【税込3980円以上で送料無料】 【レビュー投稿で100円OFFクーポン】【お取り寄せ】ドクター・ショール 消臭・抗菌靴スプレー 無香性 300mL ケア くつ シューズ 日用雑貨 [ショップ:ココデカウ] [ショップコード:cocodecow]
価格:1,284円 税込 送料別 クレジットカード利用可 海外配送不可 翌日配送不可 ギフト包装不可
【商品説明】大容量300mL瞬間消臭+ニオイ菌繁殖阻止。消臭、抗菌、防カビ成分「コーキンマスター」が靴のニオイの元となる細菌、カビの繁殖を徹底的に抑えます。発生しているニオイも98%瞬時に除去。天然消臭成分配合。無香性タイプ。あらゆるタイプの履物にご使用いただけます。【仕様】●無香性●注文単位:1本【備考】※メーカーの都合により、パッケージ・仕様等は予告なく変更になる場合がございます。【検索用キーワード】しょーるずうぇるねすかんぱにー ショールズウェルネスカンパニー SHOLL’S WELLNESS COMPANY SHOLLSWELLNESSCOMPANY 大型 384425 スプレー ドクターショール Dr.ショール Dr.scholl drscholl どくたーしょーる Dr.ショール消臭抗菌靴スプレー無香性300mL Dr.ショール 消臭抗菌靴スプレー 無香性 靴スプレー 消臭スプレー 抗菌スプレー 靴用 天然消臭成分 ニオイ消臭 大サイズ コンパクトサイズ 消臭 抗菌 防カビ コーキンマスター 日用雑貨 くつシューズ用品 RPUP_02 R1899C大サイズ靴スプレー
 スニ-カ-ボ-ル Sneaker Balls グッズその他 【3/1限定 2万円以上で1,500円OFF!&P10倍】 スニ-カ-ボ-ル Sneaker Balls スニーカーボール フルーツ パイン&ストロベリー 芳香剤 消臭剤 シューズ用 靴用 シューケア 部活 クラブ バッグ ロッカー 香り長持ち 玄関 靴箱 226905
スニ-カ-ボ-ル Sneaker Balls グッズその他 【3/1限定 2万円以上で1,500円OFF!&P10倍】 スニ-カ-ボ-ル Sneaker Balls スニーカーボール フルーツ パイン&ストロベリー 芳香剤 消臭剤 シューズ用 靴用 シューケア 部活 クラブ バッグ ロッカー 香り長持ち 玄関 靴箱 226905 [ショップ:山とアウトドアの店 山気分] [ショップコード:e-lodge]
価格:660円 税込 送料別 クレジットカード利用可 ショップオブザイヤー受賞店舗 海外配送不可 翌日配送不可 ギフト包装不可
素材・材質:ポリエステル、ポリプロピレン 仕様:香り/フレッシュ&クリーン 特徴:靴の中に転がすだけで気になるニオイを簡単消臭。爽やかなフレッシュ&クリーンの香りが持続します。ジムバッグ、ロッカーなどにもお使いいただけます。消臭成分はボールの中に入っているので、靴や洋服を汚す心配はありません。汗や様々なニオイを消臭します。 約90日間香りが長持ちします。 原産国:中国 注意:※用途以外には使用しないでください本品は食べられません。※万一、内容物を飲み込んだり、目に入ったりした場合には、ただちに医師の診断を受けてください。※ボールの中の内容物をさわるとかぶれることがあります。素手でさわらないでください。 詳細:※小児の手の届かないとろこに保管してください。※高温、多湿、直射日光を避けて保管してください。フレッシュ&クリーンの香りが持続!多目的に使える芳香・消臭剤。
 Sneaker Balls スニーカーボール 【3/1限定 2万円以上で1,500円OFF!&P10倍】 スニ-カ-ボ-ル Sneaker Balls スニーカーボール スポーツ ベースボール 芳香剤 消臭剤 シューズ用 靴用 シューケア 部活 クラブ ジムバッグ ロッカー 香り長持ち 玄関 靴箱 運動 221993
Sneaker Balls スニーカーボール 【3/1限定 2万円以上で1,500円OFF!&P10倍】 スニ-カ-ボ-ル Sneaker Balls スニーカーボール スポーツ ベースボール 芳香剤 消臭剤 シューズ用 靴用 シューケア 部活 クラブ ジムバッグ ロッカー 香り長持ち 玄関 靴箱 運動 221993 [ショップ:山とアウトドアの店 山気分] [ショップコード:e-lodge]
価格:660円 税込 送料別 クレジットカード利用可 ショップオブザイヤー受賞店舗 海外配送不可 翌日配送不可 ギフト包装不可
素材・材質:ポリエステル、ポリプロピレン 仕様:香り/フレッシュ&クリーン 特徴:靴の中に転がすだけで気になるニオイを簡単消臭。爽やかなフレッシュ&クリーンの香りが持続します。ジムバッグ、ロッカーなどにもお使いいただけます。消臭成分はボールの中に入っているので、靴や洋服を汚す心配はありません。汗や様々なニオイを消臭します。 約90日間香りが長持ちします。 原産国:中国 注意:※用途以外には使用しないでください本品は食べられません。※万一、内容物を飲み込んだり、目に入ったりした場合には、ただちに医師の診断を受けてください。※ボールの中の内容物をさわるとかぶれることがあります。素手でさわらないでください。 詳細:※小児の手の届かないとろこに保管してください。※高温、多湿、直射日光を避けて保管してください。フレッシュ&クリーンの香りが持続!多目的に使える芳香・消臭剤。
 スニ-カ-ボ-ル Sneaker Balls グッズその他 【3/1限定 2万円以上で1,500円OFF!&P10倍】 スニ-カ-ボ-ル Sneaker Balls スニーカーボール ブライト アソート 芳香剤 消臭剤 シューズ用 靴用 シューケア 部活 クラブ ジムバッグ ロッカー 香り長持ち 玄関 靴箱 運動 221122
スニ-カ-ボ-ル Sneaker Balls グッズその他 【3/1限定 2万円以上で1,500円OFF!&P10倍】 スニ-カ-ボ-ル Sneaker Balls スニーカーボール ブライト アソート 芳香剤 消臭剤 シューズ用 靴用 シューケア 部活 クラブ ジムバッグ ロッカー 香り長持ち 玄関 靴箱 運動 221122 [ショップ:山とアウトドアの店 山気分] [ショップコード:e-lodge]
価格:660円 税込 送料別 クレジットカード利用可 ショップオブザイヤー受賞店舗 海外配送不可 翌日配送不可 ギフト包装不可
素材・材質:ポリエステル、ポリプロピレン 仕様:香り/フレッシュ&クリーン 特徴:靴の中に転がすだけで気になるニオイを簡単消臭。爽やかなフレッシュ&クリーンの香りが持続します。ジムバッグ、ロッカーなどにもお使いいただけます。消臭成分はボールの中に入っているので、靴や洋服を汚す心配はありません。汗や様々なニオイを消臭します。 約90日間香りが長持ちします。 原産国:中国 カラー:パープル/ライトグリーン/ピンク(※アソートのため、カラーをお選びいただくことはできません) 注意:※用途以外には使用しないでください本品は食べられません。※万一、内容物を飲み込んだり、目に入ったりした場合には、ただちに医師の診断を受けてください。※ボールの中の内容物をさわるとかぶれることがあります。素手でさわらないでください。 詳細:※小児の手の届かないとろこに保管してください。※高温、多湿、直射日光を避けて保管してください。フレッシュ&クリーンの香りが持続!多目的に使える芳香・消臭剤。
| 5294件|2026-02-26更新|3ページ/100ページ
<-- 前のページへ 次のページへ --> |